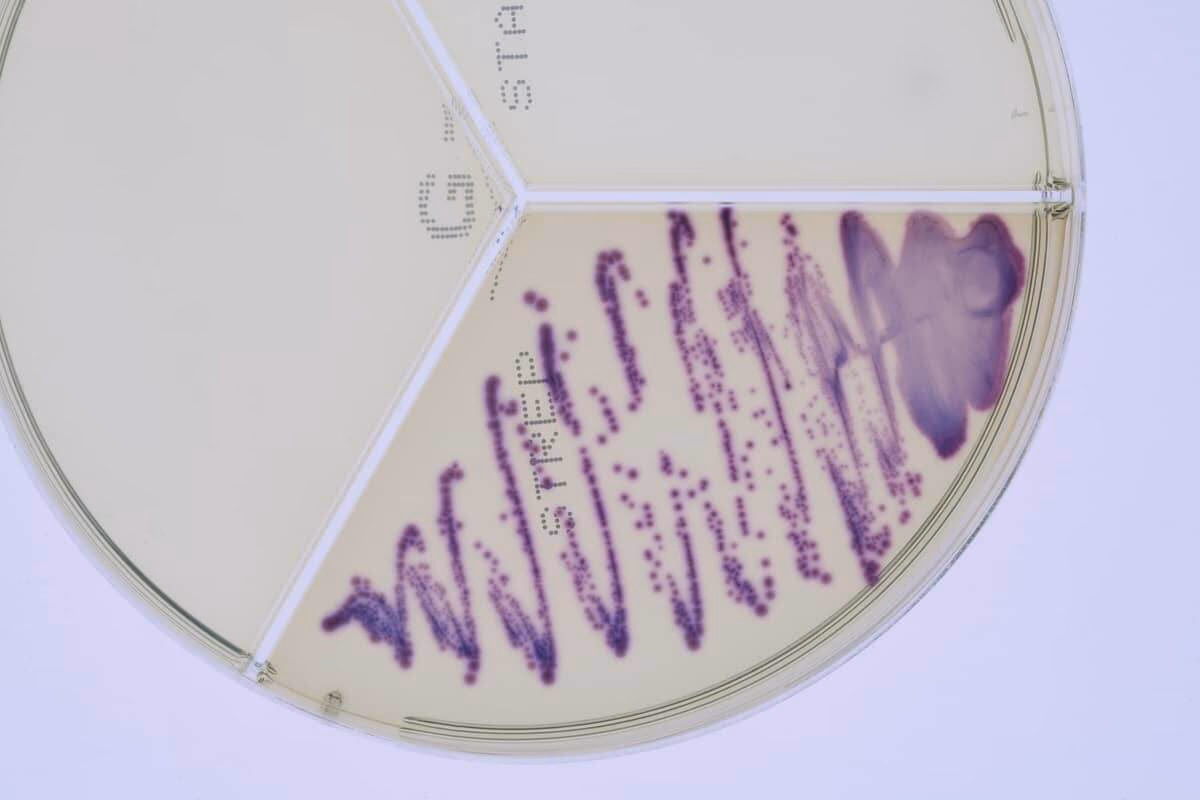
Do environmental streptococci cause mastitis?

19/11/2021
Streptococcus uberis er en velkendt og frygtet årsag til yverbetændelse, også kendt som mastitis, hos malkekvæg verden over. Denne bakterie udgør en særlig udfordring for landmænd og dyrlæger, da den kan forårsage alt fra milde, skjulte infektioner til alvorlige, akutte tilfælde. Et centralt spørgsmål har længe været, hvorfor udfaldet af en infektion varierer så meget. Ny forskning kaster lys over bakteriens snedige strategi: en bemærkelsesværdig evne til at undgå at blive opdaget af yverets primære forsvarsceller. Denne artikel dykker ned i de biologiske mekanismer, der gør S. uberis til en så succesfuld og problematisk patogen, og forklarer, hvordan den interagerer – eller undlader at interagere – med koens immunsystem.

- Hvad er Streptococcus uberis Mastitis?
- En "Magisk Kappe": Hvordan S. uberis Undgår Immunsystemet
- TLR-Signalering: Den Brudte Alarmkæde
- Et Paradoks: Isolerede Komponenter Kan Aktivere Immunforsvaret
- Makrofagerne Reagerer: Ikke Alle Celler Bliver Snydt
- Klinisk vs. Subklinisk Mastitis: En Konsekvens af Immun-Snigang?
- Ofte Stillede Spørgsmål (FAQ)
Hvad er Streptococcus uberis Mastitis?
Mastitis er en betændelsestilstand i yveret, der næsten altid skyldes en bakteriel infektion. Det er den dyreste sygdom i mælkeindustrien på grund af nedsat mælkeproduktion, omkostninger til behandling og potentielt tab af dyret. Infektioner med S. uberis er særligt problematiske. I modsætning til smitsomme patogener, der spredes fra ko til ko, er S. uberis en miljøbakterie, hvilket betyder, at den findes i koens omgivelser, såsom strøelse og jord, hvilket gør forebyggelse vanskelig.
En S. uberis-infektion kan manifestere sig på to måder:
- Klinisk mastitis: Her er symptomerne tydelige. Yveret kan være hævet, rødt og ømt, og mælken kan være klumpet, vandig eller misfarvet. Koen kan også have feber og nedsat appetit.
- Subklinisk mastitis: Denne form er mere lumsk. Der er ingen synlige tegn på sygdom hos koen eller forandringer i mælken, men infektionen er til stede. Den kan kun opdages ved at måle et forhøjet celletal i mælken. Subkliniske tilfælde er økonomisk skadelige, da de fører til et langvarigt fald i mælkeproduktionen og kan fungere som et reservoir for smitte.
Forskere har længe diskuteret, om forskellen mellem klinisk og subklinisk mastitis skyldes forskellige stammer af S. uberis med varierende virulens (evne til at forårsage sygdom), eller om det primært afhænger af den enkelte kos immunforsvar. Den seneste forskning peger kraftigt i retning af, at bakteriens grundlæggende interaktion med yvercellerne er nøglen til at forstå denne variation.
En "Magisk Kappe": Hvordan S. uberis Undgår Immunsystemet
Yverets første forsvarslinje mod indtrængende bakterier er de mælkeproducerende epitelceller (MEC'er), der beklæder mælkekirtlerne. Disse celler er ikke kun passive mælkeproducenter; de er også udstyret med sensorer til at opdage patogener og starte et immunrespons for at bekæmpe infektionen. Den mest opsigtsvækkende opdagelse er, at S. uberis generelt undlader at aktivere disse celler. Selvom epitelcellerne registrerer tilstedeværelsen af en fremmed organisme, undlader de at igangsætte den inflammatoriske alarm, der er nødvendig for at tilkalde kroppens immunceller.
Forskning, der involverede test af 14 forskellige S. uberis-stammer isoleret fra både kliniske og subkliniske tilfælde, viste et ensartet mønster: ingen af stammerne fremkaldte en signifikant immunreaktion i yverepitelcellerne. Dette gjaldt uanset om bakterierne havde en kapsel (et beskyttende slimlag) eller ej, og uanset om de var kendt som virulente eller avirulente. Det tyder på, at S. uberis har udviklet en overfladestruktur, der fungerer som en slags "magisk kappe", der skjuler de molekyler, som epitelcellernes sensorer normalt ville genkende som farlige. Bakterien er fysisk til stede, men for yverets primære vagtposter er den funktionelt usynlig.
TLR-Signalering: Den Brudte Alarmkæde
For at forstå, hvordan S. uberis opnår denne usynlighed, må vi se på de molekylære mekanismer. Celler som yverepitelceller har overfladereceptorer kaldet Toll-like receptorer (TLR'er), der fungerer som et alarmsystem. Når en TLR genkender et specifikt molekylært mønster på en bakterie (kendt som et PAMP), aktiveres en signalkæde inde i cellen. Denne TLR-signalering kulminerer i aktiveringen af transkriptionsfaktoren NF-κB, som er en slags "hovedafbryder", der tænder for gener, der producerer inflammatoriske signalstoffer (cytokiner og kemokiner).
Studier viser, at S. uberis fuldstændig undlader at aktivere denne kritiske signalkæde i yverepitelceller. Hverken varme-inaktiverede eller levende S. uberis-bakterier formåede at øge niveauet af aktivt NF-κB. Dette indikerer, at alarmen aldrig bliver slået til. Specifikt blev det bekræftet, at S. uberis ikke aktiverer TLR2, en receptor, der er afgørende for genkendelsen af mange grampositive bakterier. Alarmkæden er brudt, før den overhovedet er startet.
Et Paradoks: Isolerede Komponenter Kan Aktivere Immunforsvaret
Et fascinerende paradoks opstår, når man undersøger de enkelte komponenter af S. uberis' cellevæg. En af disse komponenter er Lipoteichoinsyre (LTA). Forskere isolerede LTA fra S. uberis og udsatte yverepitelcellerne for det rene LTA. Resultatet var slående: I modsætning til den intakte bakterie fremkaldte det isolerede LTA et meget kraftigt immunrespons i cellerne, inklusive aktivering af NF-κB.
Denne opdagelse understøtter teorien om den "magiske kappe". Det beviser, at S. uberis besidder molekyler, der er fuldt ud i stand til at alarmere immunsystemet. Men i den intakte bakteries cellevæg er disse molekyler arrangeret eller skjult på en sådan måde, at de er utilgængelige for yverepitelcellernes receptorer. Bakterien har altså potentialet til at blive opdaget, men dens overordnede arkitektur forhindrer det effektivt.
Makrofagerne Reagerer: Ikke Alle Celler Bliver Snydt
Er S. uberis fuldstændig usynlig for hele immunsystemet? Svaret er nej. Mens yverepitelcellerne, de første respondenter, bliver snydt, reagerer de professionelle immunceller helt anderledes. Forskere testede de samme S. uberis-præparater på makrofager, som er en type hvide blodlegemer, hvis primære job er at opspore, opsluge og nedbryde patogener.
I skarp kontrast til epitelcellerne reagerede makrofagerne med et kraftigt og robust immunrespons. De udtrykte høje niveauer af cytokiner og kemokiner, og NF-κB blev stærkt aktiveret. Dette viser tydeligt, at professionelle immunceller er fuldt ud i stand til at genkende S. uberis som en trussel. Forskellen ligger sandsynligvis i, at makrofager er designet til at fagocytere (opsluge) patogener, hvilket kan eksponere de skjulte molekylære mønstre, som epitelcellerne ikke kan "se" på bakteriens overflade.
Sammenligning af Immunrespons i Forskellige Celletyper
| Celletype | Genkendelse af S. uberis | Immunrespons (NF-κB aktivering) | Resultat |
|---|---|---|---|
| Yverepitelceller (MEC) | Meget svag eller ingen | Ingen eller ubetydelig | Infektionen etableres uden en tidlig alarm |
| Makrofager | Stærk | Kraftig | Inflammatorisk reaktion og bekæmpelse af bakterien |
Klinisk vs. Subklinisk Mastitis: En Konsekvens af Immun-Snigang?
Disse resultater giver en samlet og overbevisende forklaring på S. uberis' adfærd. Den manglende aktivering af yverepitelcellerne tidligt i infektionsforløbet forklarer, hvorfor en stor andel af infektionerne udvikler sig til subklinisk mastitis. Bakterien kan etablere sig og formere sig i yveret uden at udløse en kraftig betændelsesreaktion, der ville føre til synlige symptomer.
Hvad afgør så, om en infektion forbliver subklinisk eller udvikler sig til klinisk mastitis? Det tyder på, at svaret i mindre grad skal findes i bakteriens stamme og i højere grad i den enkelte kos individuelle immunstatus. En ko med et større antal residente makrofager i yveret, eller en ko, hvis immunsystem af andre årsager er mere parat til at reagere, vil måske hurtigere kunne mobilisere et forsvar. Når de professionelle immunceller endelig ankommer til infektionsstedet i stort nok antal, vil den kraftige betændelsesreaktion, de igangsætter, føre til de kliniske symptomer, vi forbinder med mastitis. Variationen i sygdommens sværhedsgrad er således sandsynligvis et resultat af en forsinket, men til sidst overvældende, immunreaktion, snarere end en forskel i bakteriens iboende aggressivitet.
Ofte Stillede Spørgsmål (FAQ)
Hvad er forskellen på klinisk og subklinisk mastitis?
Klinisk mastitis har synlige symptomer som hævelse af yveret og forandringer i mælken (f.eks. klumper). Subklinisk mastitis har ingen synlige symptomer, men infektionen er til stede og kan påvises ved et forhøjet celletal i mælken, hvilket indikerer en betændelsestilstand.
Hvorfor er S. uberis-infektioner så svære at behandle?
S. uberis' evne til at undgå tidlig opdagelse af immunsystemet betyder, at infektionen kan blive veletableret, før kroppen reagerer effektivt. Denne forsinkede reaktion gør det sværere for både antibiotika og koens eget immunforsvar at fjerne bakterien helt, hvilket ofte fører til kroniske eller tilbagevendende infektioner.
Kan S. uberis vokse i mælk?
Ja, som en mastitis-patogen er S. uberis tilpasset til at overleve og formere sig i miljøet i mælkekirtlen. Mælk udgør en rig næringskilde, som bakterien kan udnytte for at etablere en infektion.
Er alle S. uberis-stammer lige farlige?
Mens der kan være forskelle mellem stammer, tyder forskningen på, at den grundlæggende mekanisme til at undgå immunforsvaret i yverepitelcellerne er fælles for de fleste, hvis ikke alle, S. uberis-stammer. Sygdommens sværhedsgrad ser ud til at afhænge mere af den enkelte kos immunrespons end af den specifikke bakteriestamme.
Hvis du vil læse andre artikler, der ligner Streptococcus uberis og Yverbetændelse, kan du besøge kategorien Sundhed.
